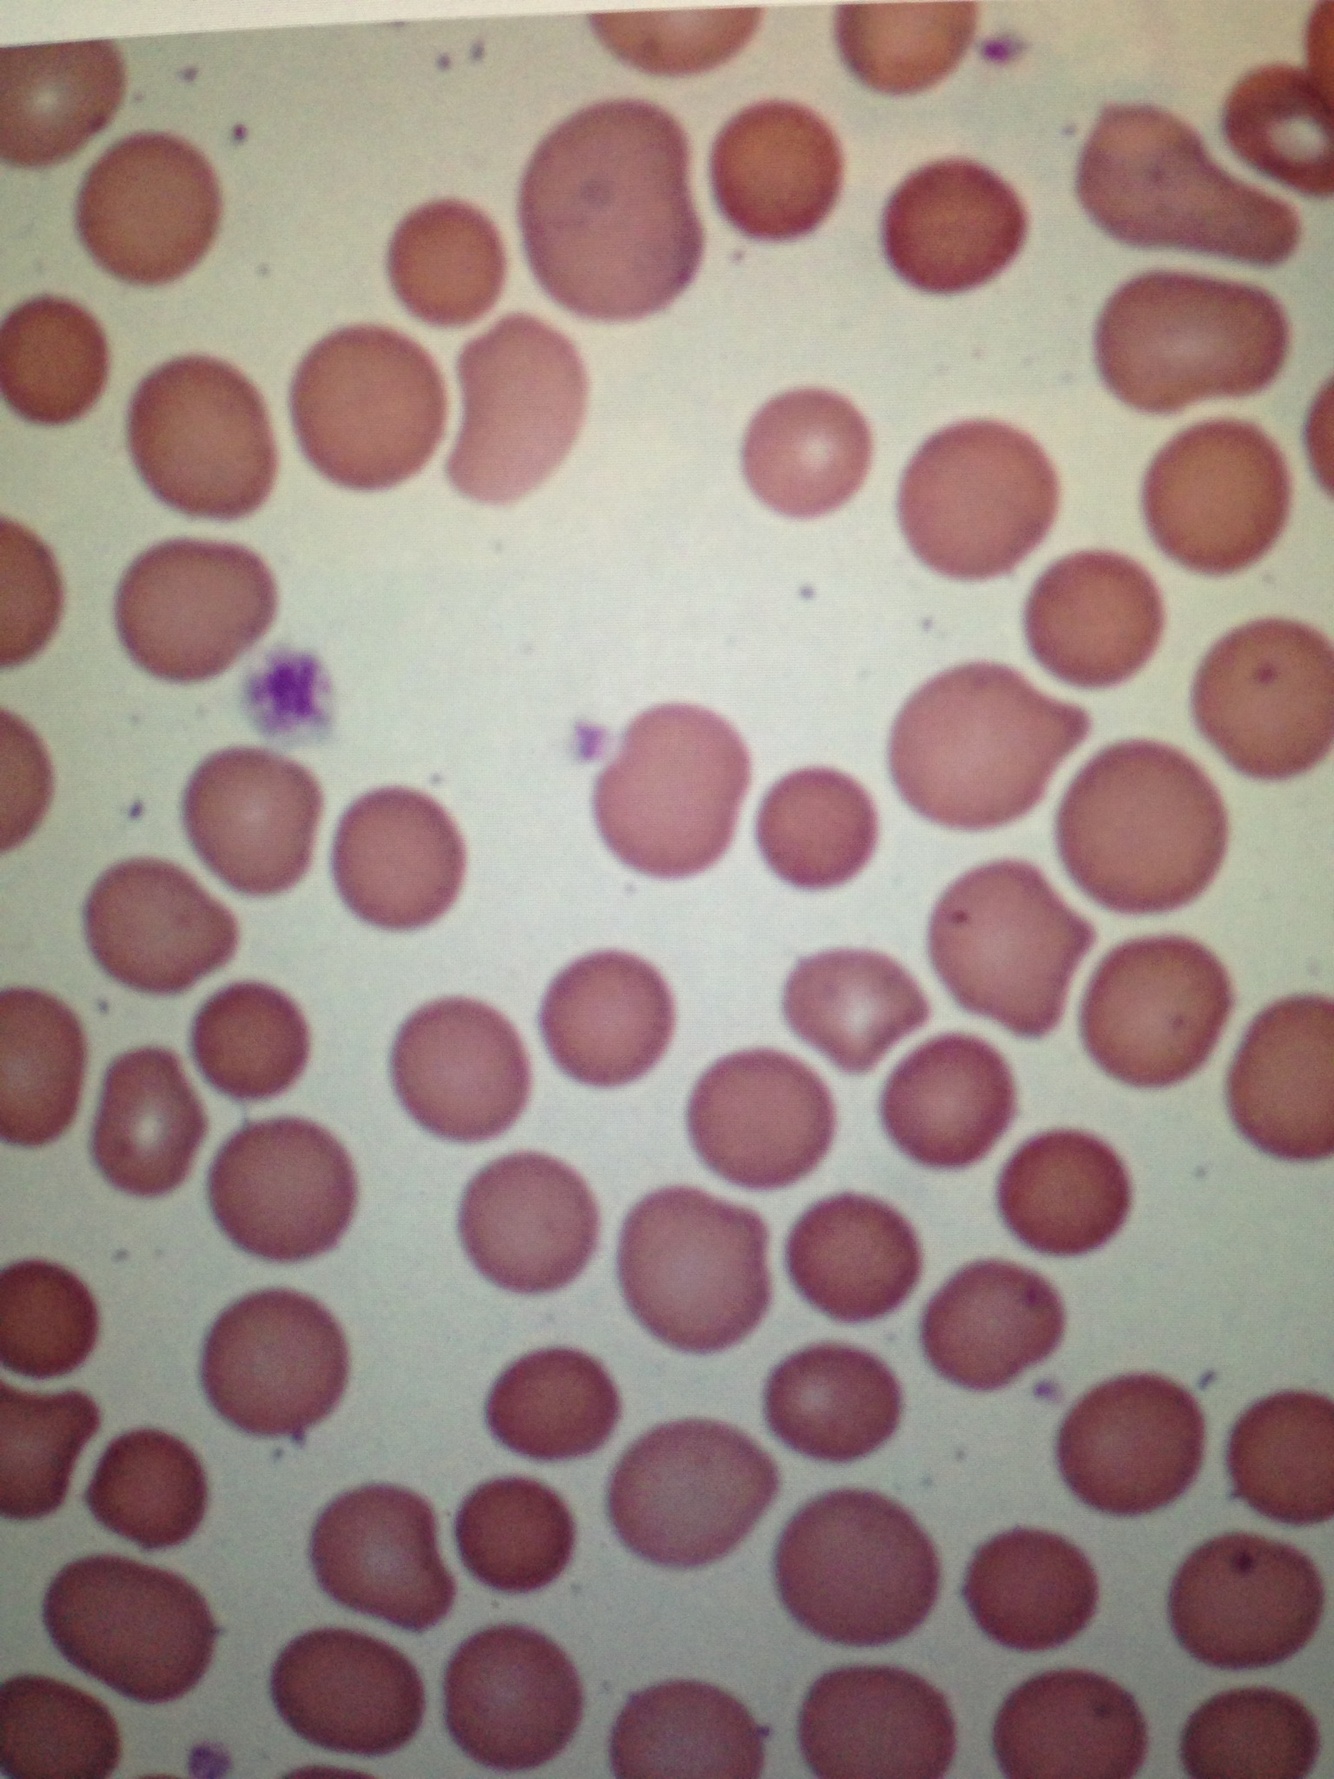

Pyruvate Kinase deficiency has what effect on RBC’s?
last step in glycolysis , no PK–> you can’t generate the ATP from glycolysis in your RBC’s, they become senescent and the spleen removes them Spleen will hypertrophy from this overwork
mTOR signaling pathway (the more this is turned on, more cancer)
growth factor binds to Tyrosine Kinase –> autophosphorylation of tyrosine –> activation of PI3K –> activation of PK-B (akt) –> akt activates mTOR –> mTOR goes to nucleus to induce genes involved in cell survival / anti apoptosis
Soon after a woman is started on Warfarin, she develops areas of skin and fat necrosis… why?
Warfarin inhibits all the vit. K dep factors (Factors 2,7,9,10 & protein C & S)—> but proteins C & S have shorter half lives & are therefore depleted first this leaves you with a period of time with no protein C (which normally INactivates factor V & VII) and plenty of the other clotting factors this sets you up for clots & “ Warfarin Skin Necrosis” —> so you must always give Heparin too for the 1st few days of warfarin therapy
Protein C function
inactivates factors V & VII by proteolysis
In HbS – what causes the Hb to be able to polymerize under low oxygen conditions and therefore “sickle”?
HbS contains a valine in place of the glutamic acid at position 6 in the beta subunit, this promotes HYDROPHOBIC INTERACTION among the Hb molecules and polymerization
HbC and Sickle cell disease are result of ________ mutations
Missense mutations (one aa sub’d for another aa) HbC = lysine for glu at position 6 HbS = valine for glu at position 6
blasts in peripheral smear w/ TdT + and PAS + material
Lymphoblasts (ex: Acute Lymphoblastic Leukemia) -CD 19 & 10 = B cell blasts -CD 1, 2, 5 = T cell blasts
blasts in peripheral smear w/ peroxidase + granules
Auer Rods – this means Myeloblasts (AML) (found abundantly in AML M3)
treatment of Tumor Lysis Syndrome (hyperkalemia, hyperphosphatemia, hyperuricemia)
Rasburicase or Allopurinol
anemia with decreased Ferritin, increased Transferrin, increased TIBC, MCV < 80
Iron deficiency anemia (microcytic, hypochromic anemia)
reasons for Burr cells on peripheral smear
Uremia, Pyruvate Kinase deficiency, Microangiopathic hemolytic anemias (TTP & HUS), or mechanical trauma to the RBC
2,3 BPG effect on O2 binding Hb
2.3 BPG allosterically decreases the affinity of Hb for O2 –> makes it easier to dump oxygen in the tissues
a pt with ESRD who has not had dialysis for over a week develops excessive bleeding when changing his catheter
Uremic platelet dysfunction - only the bleeding time will be prolonged
most commonly used drug for long term anticoagulation after a PE
Warfarin -inhibits Vit K dependent carboxylation of glutamic acid residues on the Vit K dep clotting factors & inhibits Epoxide Reductase
drug of choice for ACUTE management of DVT
Heparin (activates antithrombin III)
type of leukemia that is more likely to present with a large mass in the mediastinum or neck, and cause symptoms like dysphagia
T-cell ALL (as apposed to B-cell ALL which presents w/ fever, malaise, bleeding, bone pain, hep/splenomegaly)
in a normal distribution, _____% lie within 1 SD, _____% within 2 SD and _______% within 3 SD’d
68% – 1 SD 95% – 2 SD 99.7% – 3 SD
most common inherited bleeding disorder, causes a prolonged bleeding time and PTT
von Willebrand disease
what has the main control over Iron absorption and excretion in the body?
the liver – specifically Hepcidin -Hepcidin is increased when you don’t need to absorb any more Iron, it binds to and causes downregulation and degradation of Ferroportin
What enzyme converts Heme —> Biliverdin and is thereby responsible for the greenish color of bruises
Heme Oxygenase
woman with heavy periods, her platelet count is normal & they aggregate normally in response to ADP but not to Ristocetin
vWF deficiency
drug treatment for vWF deficiency
Desmopressin — b/c ADH stimulates the release of vWF from endothelial cells
A man with non-tender cervical lymph nodes has a biopsy shown here, cytogenetic analysis would likely show overexpression of _______________

Bcl-2
patient with mild jaundice, RBC peripheral smear is shown, the dx was made by osmotic fragility testing & an increased MCHC
Hereditary Spherocytosis
-no central pallor, spherocytes seen on smear